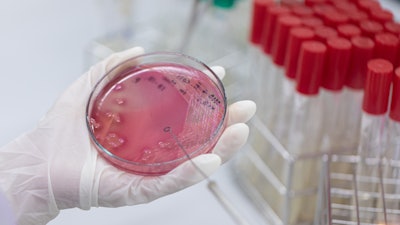

You might be old enough to remember the famous "Where's the Beef?" Wendy's commercials. This question may be asked in a different context since U.S. regulators approved the sale of lab-grown chicken meat made from cultivated cells in June 2023.
Growing animal cells in the lab isn't new. Scientists have been culturing animal cells in artificial environments since the 1950s, initially focusing on studying developmental biology and cancer. This technique remains one of the major tools in life science research, especially for drug development.
What are cell cultures?
Cell cultures are typically grown using either natural or artificial growth media. Natural media comprise naturally-derived biological fluids, whereas artificial media comprise both organic and inorganic nutrients and compounds. Both contain the necessary ingredients to foster the growth and development of cells. These ingredients typically contain nutrients such as vitamins, carbohydrates, amino acids and other molecules that provide the fuel for cells to grow and multiply.
Researchers use cells grown using tissue culture to answer a variety of experimental questions. As a biochemist, I use plant tissue culture techniques in my courses and research program. Researchers can add viruses, bacteria, fungi, hormones, vitamins and other pathogens or compounds to cells grown in culture to observe how different factors affect the cells' behavior or function, especially as it relates to which genes are turned on or off in the cell and which proteins respond to those pathogens or compounds.
In drug development, growing cells in culture is usually the first step before potential drug candidates can be tested in animals.
How is lab-grown meat made?
Researchers use similar techniques to grow meat in the lab. The process can generally be broken down into three major steps.
The first step involves removing a small number of cells – typically muscle or stem cells – from an animal during a harmless and painless procedure. Stem cells are cells from an organism that are not specialized and can be manipulated in the lab to turn into the many different types of cells of that organism.
The next step is culturing the cells. The cells are placed in an artificial environment favorable to their growth. Because of the large amount of cells that have to be grown to produce meat, the cells are incubated in a bioreactor – a steel tank that provides controlled temperature, humidity, pressure and sterile conditions – with the appropriate medium to facilitate growth. The growth media are changed a number of times to encourage the cells to differentiate and multiply into the three major components of meat: muscle, fat and connective tissue.
In last step of the process, known as scaffolding, the cells are organized and packed tightly together to create the desired size, shape and cut of meat for consumption.
Pros and cons of cultured meat
There are pros and cons to growing meat through cell culture techniques. While cultured meat may produce relatively less greenhouse gas than conventional livestock production in certain conditions, researchers need to refine the process before it can be cost-efficient and brought to scale.
A 2021 analysis estimated that lab-grown meat will cost US$17 to $23 per pound to produce, and that does not include grocery store markups. In comparison, conventionally grown ground beef typically costs a little under $5 per pound.
A 2021 McKinsey report estimates that it will take approximately 220 million to 440 million liters of bioreactor capacity to meet 1% of current protein market share, but current bioreactor capacity tops out at 200 million liters. There are also concerns about the biological limitations of growing large numbers of various cell types in the same bioreactor.
Lab-grown meat may improve animal welfare and be less likely to carry disease or cause food-borne illnesses. However, consumers may also perceive lab-grown meat to be unnatural or have concerns about its taste.
Companies are likely paying attention and adapting to the public's response. To put things in perspective, the first lab-grown burger cost $330,000 to create in 2013. The price has fallen to just under $10 per burger today, which is remarkable progress in just a decade.
This article is republished from The Conversation under a Creative Commons license.






















